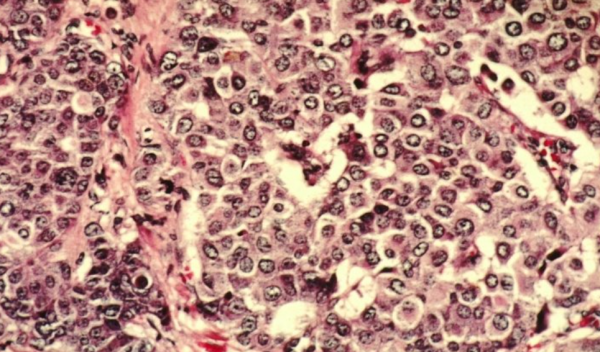
融資超72億！羅氏三連投腫瘤早篩新銳

來源:器械之家,未經授權不得以任何形式轉載,且24小時後方可轉載。
2022年1月11日癌症早篩明星公司Freenome宣佈,獲得了羅氏2.9億美元(約合人民幣19億)投資,僅一個月前公司才完成了3億美元的D輪融資,自2014年成立以來,Freenome的總融資金額已經超過了11億美元(約合人民幣72億)。
其中羅氏三次透過風險投資基金參與了Freenome的融資,據Freenome執行長Mike Nolan透露,羅氏投資總金額約為3.5億美元。
Mike Nolan曾在羅氏及其子公司工作了八年,他表示:“羅氏的支援將加強公司的多組學平臺,推動結直腸癌和早期腺瘤檢測的應用,並利用相同的平臺將下一個類別的癌症檢測推向市場。”
01
AI平臺一網打盡數十億標誌物
Freenome開發的癌症早篩多組學AI平臺,融合了腫瘤和非腫瘤訊號,包含了cfDNA基因組測序、表觀遺傳學標誌物和蛋白質標誌物的檢測,希望透過常規抽血實現多種癌症的早篩。
作為一家位於矽谷的醫療技術公司,Freenome利用最尖端的科技,透過AI分析人血液樣本中數十億遊離生物標誌物,透過對數千個癌症陽性血液樣本進行分析,多組學平臺可以學習哪些生物標誌物模式代表哪些癌症的型別和有效的治療途徑;對應的,透過對健康樣品進行訓練,多組學平臺將學習到正常的樣本組成應該是什麼樣子。
該策略結合了腫瘤和非腫瘤來源(例如免疫)特徵的多維檢視,能夠早期發現癌症,而不僅僅依賴腫瘤來源的標誌物,錯過癌症的早期跡象。
公司的第一個測試——結直腸癌,正處於臨床試驗階段,將利用融得的資金加快其商業化步伐。
目前每年約有53000名美國人死於結直腸癌,這一癌症在早期發現時存活率為90%,轉移後只有14%。
一項試驗表明,該測試在檢測1期和2期結直腸腺癌方面表現出94%的敏感性和特異性,在發現晚期癌症方面具有91%的敏感性和特異性。
此外,在識別結直腸晚期腺瘤( 可能是癌症前兆的良性息肉)時,它的敏感性為41%,與標準的Cologuard家庭糞便測試相當,遠高於其他糞便和血液測試。
公司目前在進行一項名為Preempt CRC的研究,招募了25,000名年齡在45至85歲之間的患者的血液樣本,這些患者平均具有患結直腸癌的風險且沒有該疾病的症狀。
Freenome已經開始在液體活檢平臺上開發其他測試。去年9月份發表的一項研究結果表明,其血液測試在DNA甲基化和碳水化合物抗原19-9(CA19-9)中尋找胰腺癌的跡象,能夠以93%的靈敏度檢測2期,3期和4期癌症,優於目前FDA批准的唯一用於檢測胰腺癌的測試,該測試僅能分析CA19-9訊號。
羅氏還將幫助Freenome擴大適應範圍,應用於其他癌症型別,甚至在某些情況下,能夠一次發現多種癌症。其中一些多癌症測試將在二月份開始進入臨床研究。
02
聯手西門子、谷歌
2021年12月1日Freenome宣佈與西門子醫療公司建立合作伙伴關係,在多組學和放射學乳腺癌診斷方面進行合作,共同開發用於乳腺癌血液檢測的生物標誌物,未來與乳房X光和其他標準診斷成像一起,促進乳腺癌的早期發現。
2021年4月15日西門子醫療完成了對瓦里安的收購,進一步強化了在乳腺疾病各個階段的診療技術和產品組合。
西門子醫療的MAMMOMAT Revelation乳腺X光機擁有Insight BD乳腺容積密度自動評估技術,能將乳腺密度進行分型,提供不同乳腺分型的風險評估,幫助醫生為患者制定個性化的乳腺隨診方案。
除了發達的影像產品組合外西門子也是IVD四巨頭之一(其他三家為羅氏、雅培、丹納赫),擁有免疫、生化、分子、血球、血凝、POCT 等IVD 產品線,是在 IVD 領域佈局最齊全的廠家,雙方的聯手將更深入地瞭解如何整合資料模型,利用人工智慧和基於機器學習的方法確定最有效的生物標誌物和分子特徵,以改善乳腺癌的識別。
除了西門子外,谷歌也是Freenome的合作者之一,2017年穀歌及其母公司Alphabet旗下的分支機構Verily投資了Freenome,還為其臨床團隊建立了一間實驗室。此後谷歌風投又繼續跟進了Freenome的三輪投資,被解讀為步入癌症早篩的又一佈局。
谷歌一直在研究透過其DeepMind部門識別和制定癌症治療計劃的不同方式。
2017年11月DeepMind宣佈將利用人工智慧對抗乳腺癌。這個專案的目標是,透過將機器學習應用於乳腺X光檢查,來探索新的方法以提高乳腺癌的檢測機率。DeepMind希望建立一種機器學習模型,能夠快速、準確地檢測出癌症的跡象,幫助醫生儘早發現癌症,以便儘早開始治療。
同年,公司釋出了有關腫瘤鑑定的研究,對已經轉移到鄰近淋巴結的現有乳腺癌影象集進行了演算法培訓。該演算法可以以92%的準確度檢測腫瘤,但仍然會有小几率的假陽性存在。谷歌對Freenome的投資可能加快癌症早篩領域的進展。
03
突破侷限未來或成健康指南
透過血液檢測癌症是液體活組織檢測技術領域內的一大進步,它能在身體不適之前、或者發現腫瘤瘤體之前就檢測出癌症,意義非常重大,因為早期癌症在沒有擴散之前一般都能被治癒,而且常規的抽血也不對人體造成損害。
這一技術也被《麻省理工科技評論》雜誌評為“2015年度十大突破技術”。
然而癌症有多達100多種不同型別,每種癌症還有多種亞型,具有不同的潛在分子病理生理學。這種異質性大大增加了每種癌症的篩查、診斷和治療的難度。
液體活檢領域劃分為四個方面:迴圈腫瘤DNA(cfDNA)、迴圈腫瘤細胞(CTC)、細胞外囊泡(EV)和其他。
以cfDNA——循環遊離DNA或者細胞遊離DNA為例,cfDNA是釋放到血漿中的降解的DNA片段。正常人體的cfDNA主要透過細胞凋亡過程中產生的小而均勻的185~200 bp小片段DNA。而腫瘤壞死的組織細胞由於非正常的凋亡過程,導致產生大小不同且大於200 bp的大片段DNA。迴圈中的cfDNA分子被迅速清除,半衰期為1小時或更短。
ctDNA檢測是目前市場上最常見的液體活檢形式,它在具備巨大潛力的同時,在檢測開發和臨床應用的推廣方面也面對著一系列挑戰。健康人外周血中cfDNA濃度大都小於100 ng/ml,平均值約為30 ng/ml。而在腫瘤患者體內,外周血cfDNA濃度可高達到1 000 ng/ml,平均值約為180 ng/ml。在其他的一些疾病,包括術後、寄生蟲病、心血管疾病等也可見cfDNA水平的升高。
目前cfDNA檢驗應用於臨床常規的瓶頸主要集中於方法學和樣本的質量上,由於血漿中存在的靶cfDNA微乎其微,標本的採集、抗凝劑使用和儲存的不當都會影響檢測的質量,造成假陽性或假陰性的結果。
這些都是檢測血液癌症標誌物的巨大挑戰,而AI演算法的加入,為這一難題提供瞭解決的方案。
Freenome的技術是基因組學研究和演算法的深度融合。Freenome的檢測目標是身體億萬個細胞中血液(自由細胞)中遺傳物質流的動態集合,是身體活細胞基因組在時間和空間上的變化。Freenome會檢測血液中所有的基因材料,而非僅跟蹤幾個已確定與癌症相關的基因突變。
檢測範圍的增加也提升了結果的準確度。
CEO兼聯合創始人Gabe Otte曾解釋道:“我們最特別的一點,在於我們的技術可以解答更多的問題,因為跟蹤的生物指標更多。Freenome想回答的,不止是‘患癌’、‘未患癌’這種非黑即白的問題,還有‘良性’還是‘惡性’,甚至患癌組織的位置。”
公司建立了名為Adaptive Genomics Engine (AGE)的學習引擎,可以廣泛和全面的分析基因健康。AGE學習庫不斷學習擴充,檢測的次數越多,檢測結果也就越精準,越詳細。最終不僅可以檢測疾病/健康,還可檢測出患癌的位置和癌症的類別。
甚至在對血樣的遺傳資訊與資料庫中遺傳資訊分析後,還可以得出血樣主人患癌的可能性,作為作為人體健康的檢測系統,幫助人們做出更好的健康選擇,實現精準化醫療。
04
人工智慧開啟百億市場
雖然癌症早篩對癌症的早識別早治療具有很大的價值,但考慮到目前癌症篩查比如X光檢查等對人體造成的健康風險,美國預防服務工作組(USPSTF)建議僅篩查四種癌症(宮頸癌,結腸直腸癌,乳腺癌和肺癌),甚至建議不要篩查三種癌症(卵巢癌,胰腺癌和甲狀腺癌),並指出篩查沒有淨收益或危害大於益處。
而液體活檢,作為對人體無害的篩查方式,具有極大的潛力。
2016年6月1日,美國FDA批准了首個基於EGFR基因突變“液體活檢”方法——羅氏cobas EGFR Mutation Test v2,用於檢測非小細胞肺癌(NSCLC)患者EGFR外顯子19缺失和外顯子21的L858R替代突變。
這一舉動讓液體活檢技術衝破了重重屏障,首次以高姿態展現在大眾面前,也進一步推動了液體活檢的商業化程序
據BCC分析,2020年液體活檢市場值將達220億美元,中國也預計會有200億人民幣的市場。測序巨頭Illumina前執行長Jay Flatley此前在接受媒體採訪時曾表示,液體活檢的市場規模至少達400億美元,這項技術可能是癌症診斷領域最激動人心的突破。
目前市面上基於血液的癌症早篩公司分為泛癌種和單一癌症兩類。
泛癌種的代表企業有Grail、Thrive、Freenome、Exact等。其中Grail曾被Illumina拆分,又以80億美金重新收回,其產品Galleri可以篩查超過50種類型的癌症,並展開了規模超大的臨床試驗。
截止至2020年8月底,已經入組11.5萬人群,且已公佈約9,500名受試者的臨床研究資料。在CCGA-2研究中,Galleri對於I-III期所有癌症檢測的敏感性達44%,對於12種致死率高的特定腫瘤型別,敏感性可以提升至67%;整體的檢測特異性達99.3%(0.7%的假陽性率)。
具有代表性單癌種早篩公司有Exact Science、Guardant Health、和瑞基因。Freenome的多癌種篩查尚未有資料披露,因此暫列為單癌種。
得益於人工智慧的深度學習技術Freenome的標誌物類別最多,透過分析人基因組中的規律,透過檢測到傳統醫療手段無法發現的隱藏關聯性,從而達到預知疾病、診斷疾病和甚至確定病發部位的目的,代表了最新的技術路線,和極大的發展前景,值得我們持續關注!